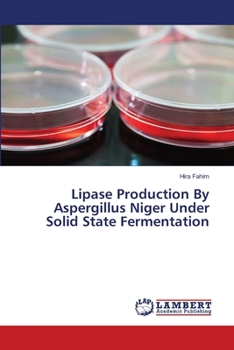
Paperback Lipase Production By Aspergillus Niger Under Solid State Fermentation Book

Lipase Production By Aspergillus Niger Under Solid State Fermentation
Animal feed industry is one of the most important segment of the agriculture sector of Pakistan. Due to high economic burden on animal producers, there is a need of more efficient consumption of... This description may be from another edition of this product.
Format:Paperback
Language:English
ISBN:3659394912
ISBN13:9783659394911
Release Date:June 2013
Publisher:LAP Lambert Academic Publishing
Length:56 Pages
Weight:0.21 lbs.
Dimensions:0.1" x 6.0" x 9.0"
Customer Reviews
0 rating